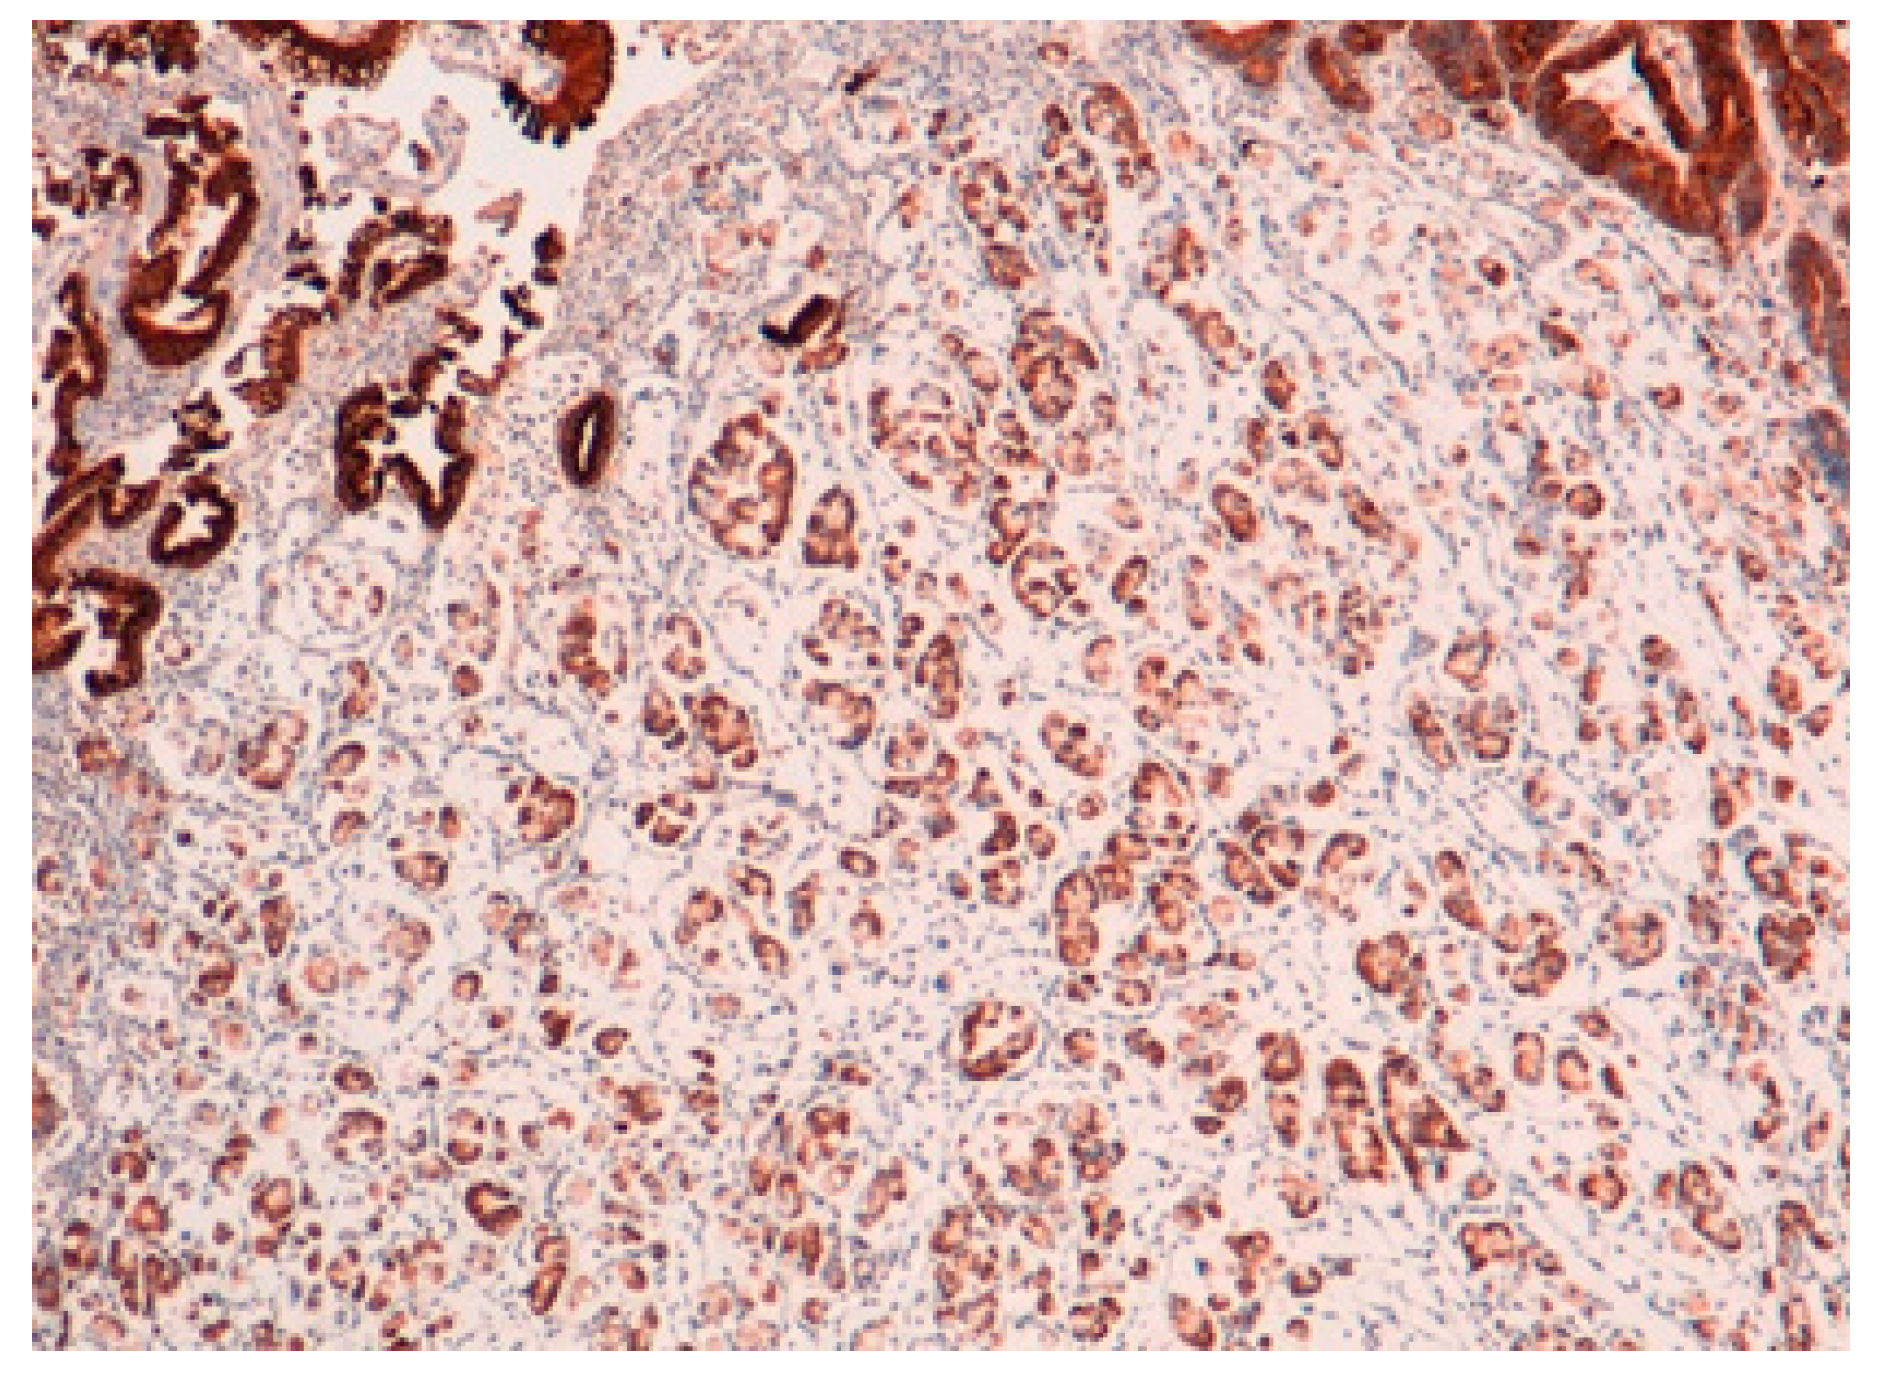
Ijms 22 06652 g002

Molecular Alterations in Gastric Preneoplastic Lesions and Early Gastric Cancer
Abstract
1. Introduction
2. Mucins Expression in Normal Gastric Mucosa
3. Gastric Mucosal Atrophy
4. Intestinal Metaplasia
5. Gastric Dysplasia
5.1. Gastric Adenoma
5.2. Gastric Pyloric Gland Adenomas
5.3. Oxyntic Adenomas
6. Early Gastric Cancer
7. Conclusions
Author Contributions
Funding
Institutional Review Board Statement
Informed Consent Statement
Data Availability Statement
Conflicts of Interest
References
- Sung, H.; Ferlay, J.; Siegel, R.L.; Laversanne, M.; Soerjomataram, I.; Jemal, A.; Bray, F. Global cancer statistics 2020: GLOBOCAN estimates of incidence and mortality worldwide for 36 cancers in 185 countries. CA Cancer J. Clin. 2021. [CrossRef]
- Arnold, M.; Park, J.Y.; Camargo, M.C.; Lunet, N.; Forman, D.; Soerjomataram, I. Is gastric cancer becoming a rare disease? A global assessment of predicted incidence trends to 2035. Gut 2020, 69, 823–829. [Google Scholar] [CrossRef]
- Heer, E.V.; Harper, A.S.; Sung, H.; Jemal, A.; Fidler-Benaoudia, M.M. Emerging cancer incidence trends in Canada: The growing burden of young adult cancers. Cancer 2020, 126, 4553–4562. [Google Scholar] [CrossRef]
- Padmanabhan, N.; Toshikazu, U.; Patrick, T. How to stomach an epigenetic insult: The gastric cancer epigenome. Nat. Rev. Gastroenterol. Hepatol. 2017, 14, 467–478. [Google Scholar] [CrossRef]
- Yasui, W.; Nahoide, O.; Kazuhiro, S.; Naoya, S.; Junichi, M. Transcritpome dissection of gastric cancer: Identification of novel diagnostic and therapeutic targets from pathology specimens. Pathol. Int. 2009, 59, 121–136. [Google Scholar] [CrossRef]
- Yasui, W.; Sentani, K.; Sakamoto, N.; Anami, K.; Naito, Y.; Oue, N. Molecular pathology of gastric cancer: Research and practice. Pathol. Res. Pract. 2011, 207, 608–612. [Google Scholar] [CrossRef] [PubMed]
- Sekine, S.; Shibata, T.; Yamauchi, Y.; Nakanishi, Y.; Shimoda, T. Beta-catenin mutations in sporadic fundic gland polyps. Virchows Arch. 2002, 440, 381–386. [Google Scholar] [CrossRef] [PubMed]
- Matsubara, A.; Sekine, S.; Kushima, R.; Ogawa, R.; Taniguchi, H.; Tsuda, H.; Kanai, Y. Frequent GNAS and KRAS mutations in pyloricgland adenoma of the stomach and duodenum. J. Pathol. 2013, 229, 579–587. [Google Scholar] [CrossRef] [PubMed]
- Fassan, M.; Simbolo, M.; Bria, E.; Mafficini, A.; Pilotto, S.; Capelli, P.; Bencivenga, M.; Pecori, S.; Luchini, C.; Neves, D. High-throughput mutation profiling identifies novel molecular dysregulation in high-grade intraepithelial neoplasia and early gastric cancers. Gastric Cancer 2014, 17, 442–449. [Google Scholar] [CrossRef]
- Min, B.-H.; Hwang, J.; Kim, N.K.; Park, G.; Kang, S.Y.; Ahn, S.; Ahn, S.; Ha, S.Y.; Lee, Y.K.; Kushima, R.; et al. Dysregulated Wnt signalling and recurrent mutations of the tumor suppressor RNF43 in early gastric carcinogenesis. J. Pathol. 2016, 240, 304–314. [Google Scholar] [CrossRef] [PubMed]
- Lauren, P. The two histological main types of gastric carcinoma: Diffuse and so-called intestinal-type carcinoma. An attempt at a histo-clinical classification. Acta Pathol. Microbiol. Scand. 1965, 64, 31–49. [Google Scholar] [CrossRef] [PubMed]
- Sugai, T.; Habano, W.; Uesugi, N.; Jao, Y.-F.; Nakamura, S.; Habe, K.; Takagane, A.; Terashima, M. Three independent genetic profiles based on mucin expression in early differentiated-type gastric cancers-a new concept of genetic carcinogenesis of early differentiated-type adenocarcinomas. Mod. Pathol. 2004, 17, 1223–1234. [Google Scholar] [CrossRef]
- Bass, A.J.; Thorsson, V.; Shmulevich, I.; Reynolds, S.M.; Miller, M.; Bernard, B.; Hinoue, T.; Laird, P.W.; Curtis, C.; Shen, H. Comprehensive molecular charaterization of gastric adenocarcinoma. Nature 2014, 513, 202–209. [Google Scholar]
- Japanese Gastric Cancer Association. Japanese Gastric Cancer Treatment Guidelines 2018, 5th ed. Gastric Cancer 2021, 24, 1–21. [Google Scholar] [CrossRef]
- Blair, V.; McLeod, M.; Carneiro, F.; Coit, D.G.; D’Addario, J.L.; van Dieren, J.M.; Harris, K.L.; Hoogerbrugge, N.; Oliveira, C.; van der Post, R.S. Hereditary Diffuse Gastric Cancer: Update clinical practice guidelines. Lancet Oncol. 2020, 21, e386–e397. [Google Scholar] [CrossRef]
- Correa, P. Human gastric carcinogenesis: A multistep and multifactorial process—First American Cancer Society Award Lecture on Cancer Epidemiology and Prevention. Cancer Res. 1992, 52, 6735–6740. [Google Scholar] [PubMed]
- Rugge, M.; Meggio, A.; Pennelli, G.; Piscioli, F.; Giacomelli, L.; de Pretis, G.; Graham, D.Y. Gastritis staging in clinical practice: The OLGA staging system. Gut 2007, 56, 631–636. [Google Scholar] [CrossRef] [PubMed]
- Reis, C.A.; David, L.; Correa, P.; Carneiro, F.; de Bolós, C.; Garcia, E.; Mandel, U.; Clausen, H.; Sobrinho-Simões, M. Intestinal metaplasia of human stomach displays distinct patterns of mucin (MUC1, MUC2, MUC5AC, and MUC6) expression. Cancer Res. 1999, 59, 1003–1007. [Google Scholar] [PubMed]
- Kerckhoffs, K.G.P.; Liu, D.H.W.; Saragoni, L.; van der Post, R.S.; Langer, R.; Bencivenga, M.; Iglesias, M.; Gallo, G.; Hewitt, L.C.; Fazzi, G.E.; et al. Mucin expression in gastric- and gastro-oesophageal signet-ring cell cancer: Results from a comprehensive literature review and a large cohort study of Caucasian and Asian gastric cancer. Gastric Cancer 2020, 23, 765–779. [Google Scholar] [CrossRef]
- Shankar, V.; Gilmore, M.S.; Elkins, R.C.; Sachdev, G.P. A novel human airway mucin cDNA encodes a protein with unique tandem-repeat organization. Biochem. J. 1994, 300 Pt 2, 295–298. [Google Scholar] [CrossRef]
- Kim, Y.S.; Gum, J., Jr.; Brockhausen, I. Mucin glycoproteins in neoplasia. Glycoconj. J. 1996, 13, 693–707. [Google Scholar] [CrossRef]
- Silva, E.; Teixeira, A.; David, L.; Carneiro, F.; Reis, C.A.; Sobrinho-Simões, J.; Serpa, J.; Veerman, E.; Bolscher, J.; Sobrinho-Simões, M. Mucins as key molecules for the classification of intestinal metaplasia of the stomach. Virchows Arch. 2002, 440, 311–317. [Google Scholar] [CrossRef] [PubMed]
- Goldenring, J.R.; Nam, K.T.; Wang, T.C.; Mills, J.C.; Wright, N.A. Spasmolytic polypeptide-expressing metaplasia and intestinal metaplasia: Time for reevaluation of metaplasias and the origins of gastric cancer. Gastroenterology 2010, 138, 2207–2210. [Google Scholar] [CrossRef] [PubMed]
- Radyk, M.D.; Burclaff, J.; Willet, S.G.; Mills, J.C. Metaplastic cells in the stomach arise, independently of stem cells, via dedifferentiation or transdifferentiation of chief cells. Gastroenterology 2018, 154, 839–843. [Google Scholar] [CrossRef] [PubMed]
- Hibdon, E.S.; Samuelson, L.C. Cellular plasticity in the stomach: Insights into the cellular origin of gastric metaplasia. Gastroenterology 2018, 154, 801–803. [Google Scholar] [CrossRef] [PubMed]
- Joo, M.K.; Park, J.-J.; Chun, H.J. Impact of homebox genes in gastrointestinale cancer. World J. Gastroenterol. 2016, 22, 8247–8256. [Google Scholar] [CrossRef]
- Mizoshita, T.; Inada, K.; Tsukamoto, T.; Kodera, Y.; Yamamura, Y.; Hirai, T.; Kato, T.; Joh, T.; Itoh, M.; Tatematsu, M. Expression of Cdx-1 and Cdx-2 mRNAs and relevance of this expression to differentiation in human gastrointestinal mucosa—with special emphasis on partecipation in intestinal metaplasia of the human stomach. Gastric Cancer 2001, 4, 185–191. [Google Scholar] [CrossRef]
- IARC WHO Classification of Tumors. WHO Classification of Tumours. Digestive System Tumours. Fifth Edition—WHO—OMS—(Volume 1); WHO: Lyon, France, 2019. [Google Scholar]
- Safatle-Ribeiro, A.V.; Franco, K.A.; Corbett, C.E.; Iriya, K.; Zilberstein, B.; Ribeiro, U., Jr. Molecular markers of mucosa harboring gastric adenomas. Arq Gastroenterol. 2013, 50, 141–147. [Google Scholar] [CrossRef] [PubMed][Green Version]
- Murakami, T. Early cancer of the stomach. World J. Surg. 1979, 3, 685–691. [Google Scholar] [CrossRef]
- Saragoni, L.; Gaudio, M.; Morgagni, P.; Folli, S.; Vio, A.; Scarpi, E.; Saragoni, A. The role of growth patterns, according to Kodama’s classification, and lymph node status, as important prognostic factors in early gastric cancer: Analysis of 412 cases. Gastric Cancer 2000, 3, 134–140. [Google Scholar] [CrossRef]
- Saragoni, L.; Morgagni, P.; Gardini, A.; Marfisi, C.; Vittimberga, G.; Garcea, D.; Scarpi, E. Early gastric cancer: Diagnosis, staging, and clinical impact. Evaluation of 530 patients. New elements for an updated definition and classification. Gastric Cancer 2013, 16, 549–554. [Google Scholar] [CrossRef]
- Saragoni, L.; Scarpi, E.; Ravaioli, A.; Morgagni, P.; Roviello, F.; Vindigni, C.; Rausei, S.; Chiaravalli, A.M.; Fumagalli, U.; Spaggiari, P. Early Gastric Cancer: Clinical Behavior and Treatment Options. Results of an Italian Multicenter Study on Behalf of the Italian Gastric Cancer Research Group (GIRCG). Oncologist 2018, 23, 852–858. [Google Scholar] [CrossRef]
- Morgagni, P.; Solaini, L.; Saragoni, L.; Bencivenga, M.; Fumagalli, U.R.; Graziosi, L.; Marino, E.; Marrelli, D.; Rausei, S.; Rosa, F.; et al. An aggressive early gastric cancer: Kodama’s PenA type. Eur. J. Surg. Oncol. 2018, 44, 1186–1190. [Google Scholar] [CrossRef]
- Noda, S.; Soejima, K.; Inokuchi, K. Clinicopathological analysis of the intestinal type and diffuse type of gastric carcinoma. Jpn J. Surg 1980, 10, 277–283. [Google Scholar] [CrossRef]
- Tsukashita, S.; Kushima, R.; Bamba, M.; Sugihara, H.; Hattori, T. MUC gene expression and histogenesis of adenocarcinoma of the stomach. Int. J. Cancer 2001, 94, 166–170. [Google Scholar] [CrossRef] [PubMed]
- Saito, A.; Shimoda, T.; Nakanishi, Y.; Ochiai, A.; Toda, G. Histologic heterogeneity and mucin phenotypic expression in early gastric cancer. Pathol. Int. 2001, 51, 165–171. [Google Scholar] [CrossRef] [PubMed]
- Molinari, C.; Tedaldi, G.; Rebuzzi, F.; Morgagni, P.; Capelli, L.; Ravaioli, S.; Tumedei, M.M.; Scarpi, E.; Tomezzoli, A.; Bernasconi, R. Early Gastric Cancer: Identification of molecular markers able to distinguish submucosa-penetrating lesions with different prognosis. Gastric Cancer 2021, 24, 392–401. [Google Scholar] [CrossRef]
- Egashira, Y.; Shimoda, T.; Ikegami, M. Mucin histochemical analysis of minute gastric differentiated adenocarcinoma. Pathol. Int. 1999, 49, 55–61. [Google Scholar] [CrossRef] [PubMed]
- Kubota, K.; Yamada, S.; Ito, M.; Nakamura, W.; Nagayo, T. Cytoplasmic leucine naphthylamidase activity expressed in signet-ring cell car-cinoma of the stomach. J. Natl. Cancer Inst. 1977, 59, 1599–1604. [Google Scholar] [CrossRef]
- Akamatsu, T.; Katsuyama, T. Histochemical demonstration of mucins in the intramucosal laminated structure of human gastric signet ring cell carcinoma and its relation to submucosal invasion. Histochem. J. 1990, 22, 416–425. [Google Scholar] [CrossRef] [PubMed]
- Tatematsu, M.; Ichinose, M.; Miki, K.; Hasegawa, R.; Kato, T.; Ito, N. Gastric and intestinal phenotypic expression of human stomach cancers as revealed by pepsinogen immunohistochemistry and mucin histochemistry. Acta Pathol. Jpn. 1990, 40, 494–504. [Google Scholar] [PubMed]
- Tatematsu, M.; Hasegawa, R.; Ogawa, K.; Kato, T.; Ichinose, M.; Miki, K.; Ito, N. Histogenesis of human stomach cancers based on assessment of differentiation. J. Clin. Gastroenterol. 1992, 14 (Suppl. 1), S1–S7. [Google Scholar] [CrossRef] [PubMed]

| Kodama’s Types | Description |
|---|---|
| Small mucosal | |
| Mucosal (M) | Intramucosal EGCs measuring less than 4 cm |
| Submucosal (SM) | Intramucosal EGCs minimally invading submucosa measuring less than 4 cm |
| Super mucosal | |
| Mucosal (M) | Intramucosal EGCs measuring more than 4 cm |
| Submucosal (SM) | Intramucosal EGCs minimally invading submucosa measuring more than 4 cm |
| Pen (penetrating) | |
| A | EGCs massively invading submucosa with nodular pattern measuring less than 4 cm |
| B | EGCs massively invading submucosa with saw teeth pattern measuring less than 4 cm |
| Mixed | Penetrating types (A or B) measuring more than 4 cm |
Publisher’s Note: MDPI stays neutral with regard to jurisdictional claims in published maps and institutional affiliations. |
© 2021 by the authors. Licensee MDPI, Basel, Switzerland. This article is an open access article distributed under the terms and conditions of the Creative Commons Attribution (CC BY) license (https://creativecommons.org/licenses/by/4.0/).
Share and Cite
Battista, S.; Ambrosio, M.R.; Limarzi, F.; Gallo, G.; Saragoni, L. Molecular Alterations in Gastric Preneoplastic Lesions and Early Gastric Cancer. Int. J. Mol. Sci. 2021, 22, 6652. https://doi.org/10.3390/ijms22136652
Battista S, Ambrosio MR, Limarzi F, Gallo G, Saragoni L. Molecular Alterations in Gastric Preneoplastic Lesions and Early Gastric Cancer. International Journal of Molecular Sciences. 2021; 22(13):6652. https://doi.org/10.3390/ijms22136652
Chicago/Turabian StyleBattista, Serena, Maria Raffaella Ambrosio, Francesco Limarzi, Graziana Gallo, and Luca Saragoni. 2021. "Molecular Alterations in Gastric Preneoplastic Lesions and Early Gastric Cancer" International Journal of Molecular Sciences 22, no. 13: 6652. https://doi.org/10.3390/ijms22136652
APA StyleBattista, S., Ambrosio, M. R., Limarzi, F., Gallo, G., & Saragoni, L. (2021). Molecular Alterations in Gastric Preneoplastic Lesions and Early Gastric Cancer. International Journal of Molecular Sciences, 22(13), 6652. https://doi.org/10.3390/ijms22136652

